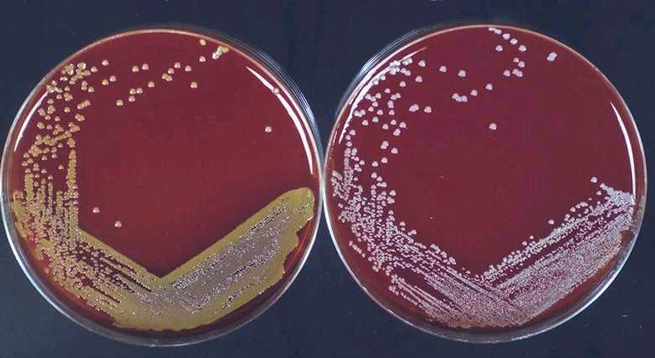

Which bugs make up your class of gram positive cocci?
Staphylococcus
Streptococci
Enterococci
Based on morphology, how do you distinguish Staph from Strept and Entero?
See below

Which enzyme does Staph have that Strept and Entero don’t?
Catalase
Staph can be further divided into coagulase +ve and coagulase -ve. Which Staph spp is in each category?
S. aureus (coag +ve)
Coagulase-negative staphylococci
S. epidermidis et al. (Device-related infections)
S. saphrophyticus (UTI)
S. lugdenensis (Native-valve endocarditis)
How do you determine if Staph is coagulase +ve or -ve?
Coag test: place down fibrinogen then a colony of each organism. If +ve, takes fibrinogen to insoluble fibrin which is clumpy, and if neg, you get a milky substance

Which bug has the white colonies and which one has the yellow colonies?
What does the area of black around the yellow colonies indicate?
S aureus - yellow
S epidermidis - white
Staph aureus – gold (the area of black can actually be seen thru = beta hemolysis)
Epidermidis doesn’t have same level of beta hemolysis
What 2 factors does S. aureus have that allow it to evade the host immune system?
Has polysaccharide capsule – avoid phagocytosis
Protein A – binds antibodies at Fc region, rendering the Ab inactive

Protein A belongs to a group of adhesion molecules for Staph. What’s the group called?
“Microbial surface components recognizing adhesive matrix molecules”
Includes Protein A
Describe the functions of the following enzymes:
Coagulase
Hyaluronidase
Promotes bacterial spread/invasion thru tissues:
Coagulase – microthrombus formation (provides an environment where the organism can actually live and seed)
Hyaluronidase - hydrolyzes hyaluronic acid
How does having the catalase enzyme improve bacterial survival for Staph?
Describe the functions of the following enzymes involved in tissue destruction:
Fibrinolysin
Lipase
Nuclease
•Improves bacterial survival
Catalase - removes hydrogen peroxide
•Tissue Destruction
Fibrinolysin - dissolves fibrin clots
Lipases - hydrolyzes lipids
Nucleases - hydrolyzes DNA
What is the role of cytotoxins in Staph virulence? Name the 2 types of cytotoxins produced by S. aureus
Cytotoxins:
Hemolysins (RBCs) and Leukocidin (WBCs)
Lyse cell membranes (of specific cell lines)
Destroy leukocytes, erythrocytes, macrophages
Describe the function of cytolytic peptides in S. aureus
Recruit then lyse neutrophils
**Overproduced in community-associated MRSA**
Name the syndrome/condition ass’d with each of the following toxins:
Exfoliative toxins
Enterotoxin
Toxic Shock Syndrome Toxin I
Exfoliative toxins >> Scalded Skin Syndrome
Enterotoxin >> Food Poisoning
Toxic Shock Syndrome Toxin I >> Sepsis
Cutaneous pyogenic diseases caused by Staph aureus include impetigo, folliculitis, furuncles, carbuncles and wound infections. Describe each of the above
Impetigo – honey crusted surface-level infection seen in children (due to staph or strept)
Folliculitis – Staph aureus can progress to folliculitis where the follicles (hair) are inflamed
Furuncle – infected and inflamed follicle that spreads further)
Carbuncles – multiple furuncles
Wound infections – from incisions, for example

Invasive pyogenic conditions caused by S. aureus include pneumonia, ___, osteomylitis and ___, all of which can result from skin infection or direct inoculation
Invasive pyogenic conditions caused by S. aureus include pneumonia, endocarditis, osteomylitis and septic arthritis, all of which can result from skin infection or direct inoculation
How do you evaluate endocarditis in a Staph infection and what is the treatment?
If Staph is found in the blood stream, you do an echocardiogram to see if there’s pathology in the heart valves
Treatment: Requires high antibiotic levels given IV to treat endocarditis
Which Staph toxin mediated syndrome results from dissemination of exfoliative toxins leading to splitting of the stratum granulosum and subsequent sterile blisters and skin scalding?
Staphylococcal scalded skin syndrome
Happens commonly in babies
Colonization on umbilical cord or infection
Common in people without immunity, due to exotoxin dissemination such that the stratum granulosum starts to split (translation: the superficial skin is literally coming apart)
No scarring because its higher up in skin layer

A localized form of Staph Scalded Skin Syndrome is ___. It results from local spread from infected wound. The disyndrome is characterized by blisters with bacteria, inflammatory cells and systemic symptoms
Bullous Impetigo
(see below)
**note that this is basically SSSS in adults**

___ is characterized by acute onset N/V, diarrhea and abd pain w/o fever
Staphylococcal Food Poisoning
Due to ingestion of pre-formed toxin (no real invasion)
Enterotoxins are heat and acid stable; interact with vagal emetic receptors (N/V)
Self limited illness
Treatment is supportive
Staphylococcal ___ ___ Syndrome is an acute onset syndrome that is characterized by a diffuse erythematous rash, fever and hypotension. The most common cause of this syndrome is ___
Staphylococcal Toxic Shock Syndrome is an acute onset syndrome that is characterized by a diffuse erythematous rash, fever and hypotension. The most common cause of this syndrome is TSST1.
**Can be production of toxin but generally result of progressive tissue infection
TSST1 is a superantigen that leads to septic shock**

Coag negative Staph (e.g. Staph epidermidis) has many of the same virulence factors as S aureus except 2. Name 2 differences between these 2 bugs
Coag negative Staph forms a slime layer (biofilm) and it has no (or very few) toxins
**Not same tissue destruction seen with S. aureus**
S epidermidis is known to cause infection of ___ material
UTIs and pyelonephritis are commonly ass’d with ___ (Staph type) infection
S ludgenensis can be found in infections of (native/prosthetic) heart valves
Infections of prosthetic material (that #biofilm)
S epidermidis is known to cause infection of prosthetic material
UTIs and pyelonephritis are commonly ass’d with S saphrophyticus (young women with fancy UTIs smell like safron) infection
S ludgenensis can be found in infections of native heart valves

When would you give empiric therapy?
Which antibiotic would you give if the patient is relly sick and you suspect bacteremia or an invasive infection?
Which antibiotic would you give if the patient is not that sick and has a skin/soft tissue infection?
Empiric therapy: when you don’t yet know the organism that’s the cause of disease
•Is the patient sick?
–YES, suspect bacteremia/invasive infection: vancomycin, daptomycin [not in pneumonia]
•maybe linezolid, ceftaroline
–NO: outpatient skin/soft tissue: clindamycin, TMP/SMX, doxycycline, linezolid
•maybe dalbavancin or oritavancin
For definitive Staph treatment, the 1st line of therapy if the bug is susceptible is __
•FIRST line:
–Anti-staphylococcal penicillins
–Oxacillin, cefazolin



